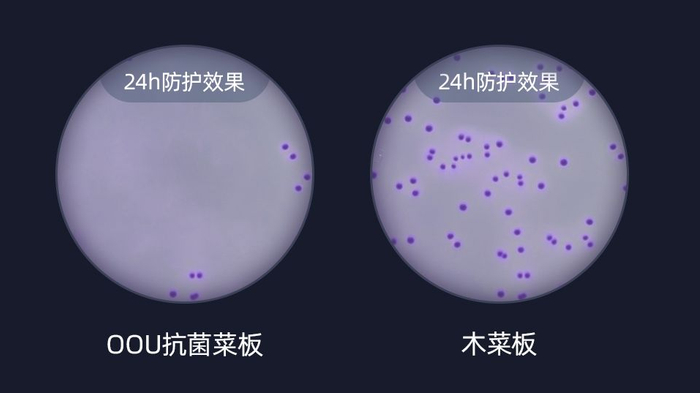

原标题:你家砧板该换了!它抗菌不发霉,做菜省心又健康
有人间烟火味的地方大概就是厨房了,一道道汁肥鲜美的美味佳肴就从这个地方的菜板上诞生。
而很多人家里的菜板其实都用了好几年也一直没有换过,但切菜板所含细菌却是马桶的3倍!
若不注意卫生,几乎每1cm²木头上就住着200万个葡萄球菌,几万个大肠杆菌!所以才会吃坏肚子。
所以,你家的菜板子真的该换了!今天就给你推荐一款不发霉且99%抑菌的多功能砧板!
\OOU厨房抑菌多功能砧板/

推荐理由:
1、日本黑科技长效抑菌99%不发霉也不伤刀!让家人吃的更健康。
2、多重功能更多体验:能磨刀,能打泥,还控水,而且可以当果盘!
3、防滑边缘切菜更稳定,轻松翻转一手就能拎得动,也很方便收纳。
粉丝优惠价¥98 商城售价¥129
日本进口高密度韧性材料
99%抗菌不发霉
相信每个人家里的厨房都少不了砧板,但不知道大家有没有仔细看过自家的菜板?
又脏又旧,一用就是好多年。但其实真的该换了,老话不都讲病从口入么,一不小心,肠胃问题就会不请自来。
有了黑科技Ag+防护
就能持久抑菌不发霉
老旧砧板不仅会滋生有害菌群,还会掉木屑开裂。时间久了就发霉导致腹泻等问题。
而普通的塑料菜板又会含有大量塑化剂,会引起呼吸道等问题,严重了更会致癌。

但是OOU抗菌砧板采用的则是日本进口抗菌黑科技Ag+防护,久用也不发霉。
板面是食品级高分子合成材料做成,高密度韧性好不伤刀防霉也抗菌,也不容易藏污纳垢。

就算是阴雨天气,也不会像木菜板那样受潮发霉。随时用都不会让食材变得不新鲜。
对于伤害人体肠胃的大肠杆菌和金黄色葡萄球菌,更是可以99%抑制滋生。

而且经过了SGS的严格实验检测,质量绝对过关。不用再担心细菌的滋生影响你和家人的健康,
24h对比测试抑菌率就能达到99%
不仅抗菌可以达到99%,而且砧板软硬适中, 一点也不伤刀。
主要采用具有弹性韧性很好的TPR材料和环保材质麦香料加工制成,所以比普通砧板更加好用,舒适度更高。
切菜切肉都毫无压力


每次切完菜再洗菜板的时候就特别费劲,而且洗不干净再切别的菜还特别容易串味。
尤其是洗火龙果,普通的木砧板用完后擦不干净也就算了。但也洗不干净就有点难受了啊。

但是OOU的抗菌砧板甚至不用洗,轻松一擦就能变得超干净。

冲洗起来也更方便,而且一点残留都没有。当然也就不会发生串味招虫子等问题啦~

99%抗菌不容易发霉还很好清洗的砧板真的太好用了。还能守护你和家人的健康~

粉丝优惠价¥98 商城售价¥129
抗菌砧板竟然还能磨刀?
打泥,控水,当果盘!
说到砧板,搭配使用的菜刀在我们的生活里“出镜率”也是很高!
但菜刀用的时间长了总得磨吧,很多人家里都是一块厚重的磨刀石或者网上专门买的磨刀神器。

可是磨刀石和磨刀用具不仅拿起来重使用起来不方便,问题是放哪都有点占地。
而且操作起来非常不安全,很容易划伤自己的手。
但你如果有了OOU抗菌砧板,就能一步解决这些问题了。

能磨刀的砧板你见过么?
从此摆脱磨刀石这个厚重的“玩意”,不论是大刀还是小刀,轻松从侧面插入,单向抽拉就可以。

磨完的刀又亮又快,切起东西来别提多舒坦了,真的超级好用!

而且磨完的刀也不容易生锈,保护了刀刃的同时也延长了刀具的使用寿命。
尤其是一些热爱厨房生活的“高端玩家”的刀,再也不会因为生锈而感到心疼了,又能开心做饭啦~

日常打泥,还能给小孩做辅食
平时做菜弄个蒜泥就老费劲了,先拍扁再切碎再压,弄完了折腾的一身汗。
但是OOU抗菌菜板还附带了打泥功能,可以打蒜泥,弄姜末,还能打各种泥。

平时家里人一块包饺子弄个姜末吧,因为里面有好多纤维丝就很费劲。
所以弄完的姜末都很大块吃起来口感就有点不太好了。但OOU抗菌菜板研磨功能出来的就非常细腻。

还可以打各种水果泥,蔬菜泥,家里有宝宝的还可以搜搜食谱给孩子做个果泥。

营养丰富又细腻,一步就能解决孩子的挑食问题啦~

粉丝优惠价¥98 商城售价¥129
家里来“且”了?
拿出来洗个杯子摆个果盘
家里面要是客人来了,这个砧板的超高颜值也让你倍有面子。
不仅正面能用,把砧板转个面也照样还能用。凹槽设计可以做杯垫,轻松沥水,让桌子保持干净!

超高颜值还能当果盘,摆在桌子上看着就很好吃。而且美观又大方。

凹槽设计疏水效果也超级好,水流会形成涡旋顺着小孔直接流走,用完一冲就干净。

作为一个厨房用的砧板,能抗菌就已经很厉害了。居然还能一件解锁这么多功能,超级实用!
耐热100℃边缘防滑更稳固
一手拎起一步收纳
在家的时候如果要是想烤个东西吃的话,塑料菜板一烫就变形,木菜板细菌又很多。
但你有了OOU抗菌砧板就不存在这些问题啦,耐热PP材质,能耐100℃高温,不变形也不会滋生细菌。

砧板使用起来舒适也很重要,如果把食材放在砧板上刚一切,砧板就滑动食材也就“飞”了。

这样一来不仅使用感极差,还会不经意间加大菜刀和砧板之间摩擦的声音。
这简直对于热爱料理的人说,就是一种有声的折磨。
所以说防滑也很重要,可以让制作美食这件事得到双倍的快乐。
砧板不滑动切什么都轻而易举,尤其对于初学者来说更是非常友好。

OOU抗菌砧板的边缘采用的一种无毒无味的高分子环保材质TPR制成。
跟传统的菜板相比韧性更好,柔软防滑。体验效果极佳,还能保证使用者的安全。

OOU抗菌砧板重量也很合适,厚度也刚刚好,仅仅只有1角硬币厚。使用起来也更有质感。

拿起来也不会很沉,轻松翻转一手就能拎起来。

而且大小合适。无论你的厨房宽敞、或是拥挤,这块砧板都能放得下。
任意一个角落,挂起来或者直立在墙面都可以,一点也不占地。

一桌放心可口的饭菜,总离不开一块称心安全的砧板。
为了家人的健康着想,还是要尽早换掉用了十好几年的菜板子。
超高颜值持久抗菌不发霉的多功能砧板还可以根据自己的喜爱来挑选。
两种颜色任君挑选:仿大理石色/小麦色

优秀品质,经得起检验。不仅质量上乘,还深获欧盟美国等30多个国家和地区的认可!
更有三大售后保障:
1、运输途中破损未开封可换新
2、七天无理由退换货!
3、及时发货保证您的使用
更多买家真实好评




温馨小贴士:
1、偏远地区不包邮,港澳台及海外地区不发货,敬请理解感谢支持!
2、初次使用产生划痕属于正常现象,一般材质表面都会有轻微划痕。不影响使用。
最后,吃得健康才是最重要的,一家人在一起就是要每天开心健健康康的,花更少的钱来守护家人的健康。
粉丝优惠价¥98 商城售价¥129


